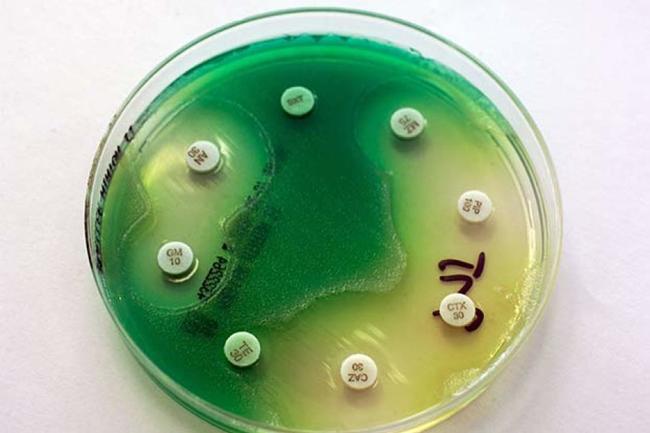
手机上最常见的10种细菌

每当我们沉迷于玩儿手机的时候,老妈就会跳出来说:“一天到晚抱着手机不放,其实手机比马桶还脏。或者会说,你的眼睛还要不要了?”这时候,大部分人都会觉得老妈言过其实。但实际上,妈妈的话并不夸张。两位科学家在2009年的一项研究中发现,因为手机会和面部、耳朵、嘴唇和手都有接触,而且使用手机的人健康状况也不一样,因此,手机早已成为了一个名副其实的病原体储存器。所以,下次当你在吃饭前用手机拍菜品时,想想那些微生物和细菌吧。那么,手机里到底有哪些常见的细菌呢? 让我们一起来看看吧。
1. 大肠菌群

下次,当你坐在马桶上起不来,不断腹泻时,想一想吧,罪魁祸首可能是你的手机。亚利桑那大学的微生物学家在2012年的一项研究中得出结论称:平均看来,智能手机上携带的细菌比马桶上的细菌还要多。有些专家表示,我们不必为此感到惊讶。因为总体说来,人类大腿上的细菌原本就比手部和口腔的细菌要少。然而,即使是有洁癖的人也往往更经常清洁厕所,而不是手机。
然而,我们还是很难忽略大肠菌群的存在。大肠菌群总是存在于人类和动物的粪便和植物的土壤中。现在,大肠菌群也毫不掩饰地存在于个人的手机上。尽管少量的这类细菌不会让你生病,但它们的存在意味着其它病原体也潜伏在手机上。
2. 大肠杆菌

和这篇文章中列出的大部分细菌一样,大肠杆菌也是我们唯恐避之不及的细菌之一。 然而,事实的真相却是,不是所有的大肠杆菌菌株都对人体有害,有些菌株甚至对人类的消化道有利。
大肠杆菌通常存在于人类的肠道之中,若这种细菌存在于手机上意味着有其它污染物的存在。此外,手机上可能会存在一种O157:H7血清型的大肠杆菌菌株。虽然它们的存在非常罕见,但正是这种病原体导致了我们在电影和当地新闻广播中听到的食源性疾病的发生。
3. 金黄色酿脓葡萄球菌

金黄色酿脓葡萄球菌是另一种常见的细菌,它的伤害性也依据菌株的不同而有差异。有的菌株会导致葡萄球菌感染等严重的皮肤疾病。比如,耐甲氧西林金黄色葡萄球菌就会导致皮肤痛疖,而且,这种细菌就是通过皮肤接触传播的。通常这种细菌在医院、医疗中心等地传播,而使用脏兮兮的手机无疑加快了这一过程。
在2009年的研究中,土耳其的微生物学家们发现在他们所测试的200人中,有超过一半的医护人员(52%)的手机都被金黄色酿脓葡萄球菌污染了。而暴露在耐甲氧西林金黄色葡萄球菌的手机则达到38%。
4. 链球菌

那天,Anderson Cooper在电脑上阅读了很多新闻,但最让他震惊的一条还是他最爱的黑莓手机在检测后被确定为粪链球菌阳性。
链球菌主要分为A型和B型两类。我们很多人在孩提时代就会遇到A类细菌,它常常引起链球菌性喉炎。同时,这种细菌还会引起更加严重的猩红热、中毒性休克综合征、蜂窝组织炎(引起皮肤肿胀的感染)和被称为坏死性筋膜炎的肉食性疾病等。B类细菌的威力也不小,它可能会引起肺炎以及尿道或皮肤感染。
5. 凝固酶阴性葡萄球菌

在介绍这一细菌之前,我们先挑战一下把它的名字快速读五遍吧。凝固酶阴性葡萄球菌是一种寄居在人体皮肤和阴道内的抗生素耐药性细菌。虽然通常来说,这种细菌比金黄色酿脓葡萄球菌伤害性要小,但却是引起血液感染的更常见原因。如果长期在医院逗留,并时常和医疗设备接触,就很有可能接触到这种细菌引起感染。根据调查发现,在与医护相关的血液感染病例中,超过30%是凝固酶阴性葡萄球菌引起的。
同时,这种细菌也出现在智能手机和其它的设备上。2011年,一群来自加纳的科学家选择来自100名随机选择的学生的手机,并从这些手机的表面提取了样本。15%的手机在凝固酶阴性葡萄球菌检测中呈阳性。
6. 霉菌

如果在冰箱里存放了四周的*草烟**还没有扔掉,那么它们一定发霉了。然而,霉菌可不仅仅指这些。 从土耳其医疗保健工作者的研究中,10%被测试的手机也被检出了霉菌。
霉菌肯定能使旧冰箱的味道变得腐败。虽然冰箱里的霉菌不如覆盖在卧室的墙上的霉菌看起来壮观,但也会造成健康问题。暴露在霉菌中可能会影响呼吸系统,导致呼吸急促、鼻塞、发热和肺部感染等问题。虽然引发肺部感染的情况并不常见。
7. 酵母菌

就像这篇文章中的一些细菌实际上有益于消化系统健康一样,酵母也具有重要功能——它可以用来制作披萨和啤酒。我们可以肯定的是,有酵母的世界更加美好。但这并不意味着你想让你的手机泡在酵母菌里。
前文提到的同一土耳其研究中,科学家在1.5%的手机中测试出了酵母菌。酵母是一种可以在身体的任何地方生存的真菌。酵母菌感染会使皮肤或阴道严重瘙痒,并导致阴道中出现分泌物。好消息是,除非用手机做了一些非常奇怪的事情,否则人们不太可能通过移动设备感染酵母菌。
8. 难辨梭状芽胞杆菌

可以说难辨梭状芽胞杆菌是一种高级而科学的“造成腹泻的原因”。老年患者或长期使用抗生素的患者尤其容易受到这种细菌的侵袭。至少现在你知道,在可预见的将来,你使用的马桶座可能相当干净。
这种细菌经常在医院传播。健康人群不太可能感染它,但每隔一段时间清洁一次手机是个不错的主意。苹果公司建议不要使用溶剂来清洁手机,只需用软布擦拭即可。其他技术专家则会把异丙醇和蒸馏水溶液喷在软布上来擦拭清洁手机。
9. 棒状杆菌

不,这不是一种会制造恶作剧的微生物。它是一种病原体。会引起一种叫白喉的具有潜在致命性的疾病。毒素会污染感染者的喉咙,使其呼吸困难。白喉病首先从感冒开始,然后病人开始发烧和发冷。最后诱发患者心脏病发作。
幸运的是,白喉疫苗在发展中国家被广泛使用。但在美国,这种疾病在很大程度上是不存在的。这意味着2014年俄勒冈大学研究人员在手机上发现的棒状杆菌可能不是有*品毒**种。
10. 铜绿假单胞菌
正如一个微生物学家团队所描述的那样,这种“机会主义病原体”能在各种各样的环境中发挥作用。它需要的营养很少,可以在不同的环境中生存。在医院的医疗设备、接收器、社区沟通工具,甚至你的谈话设备中,都能找到这种细菌的痕迹。在一项针对400部手机的研究中,尼日利亚研究人员发现这些细菌是潜伏在手机这种小器械中最常见的细菌之一。
铜绿假单胞菌与这个清单上其它细菌不同的是,这种细菌具有抵抗抗感染治疗的惊人能力。而这些感染通常发生在医院,特别是发生在重症监护病人身上。听起来,我们有必要让重症监护室成为一个无手机区了。
蝌蚪五线谱编译自 howstuffworks ,译者 晴空飞燕,转载须授权
本文为蝌蚪五线谱原创,版权归蝌蚪五线谱所有,任何媒体、网站或个人未经授权不得转载,否则追究相关法律责任。申请转载授权或合作请发送邮件至editor@kedo.gov.cn。